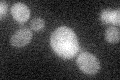
YDR528W
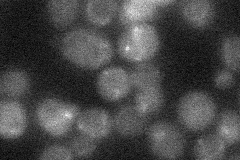
YDR528W
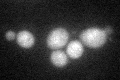
YDR528W

View description
Protein involved in regulation of cell wall composition and integrity and response to osmotic stress; overproduction suppresses a lysis sensitive PKC mutation; similar to Lre1p, which functions antagonistically to protein kinase A
Localization:
Intensity:
Fold change:
Significance:
-
C’ GFP library in SD
cytosol22.55 -
N' NOP1pr-GFP in SD

below threshold19.0806 -
N' TEF2pr-mCherry in SD

below threshold6.10729 -
N' NATIVEpr-GFP in SD
below threshold16.9784 -
N' TEF2pr-VC and Cyto-VN in SD

#N/A0 -
C’ GFP library in SD+DTT
cytosol25.971.15No -
C’ GFP library in SD+H2O2

cytosol19.920.88No -
C’ GFP library in Starvation Media

cytosol150.66No -
C’ GFP library on the background of Pup2-DaMP

cytosol -
C’ GFP library on the background of CCT mutant

cytosol22.24470.986012No
